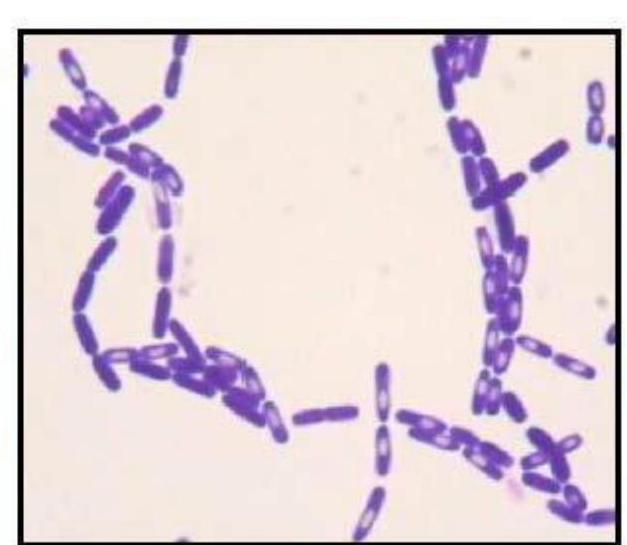
Spores en coloration de Gram

Fiche de révision : Microbiologie - Cellule bactérienne et morphologie
Introduction générale
Les bactéries sont des organismes unicellulaires procaryotes, c’est-à-dire dépourvus de noyau et d’organites membranaires complexes. Découvertes à la fin du XVII[Formule] siècle par Anton van Leeuwenhoek, elles ont été initialement appelées "animalcules". Leur rôle dans la fermentation fut démontré par Louis Pasteur au XIX[Formule] siècle, tandis que Robert Koch établit leur implication dans les maladies infectieuses, notamment en identifiant le bacille responsable de la tuberculose.
Ces microorganismes, omniprésents sur Terre, jouent un rôle écologique fondamental et peuvent être à la fois bénéfiques et pathogènes pour l’homme. Leur étude passe par la compréhension de leur morphologie, de leur structure cellulaire et de leurs caractéristiques spécifiques.
1 - Généralités sur les bactéries
1.1 - Définition et caractéristiques
- Organismes unicellulaires procaryotes : absence de noyau, génome réduit à un chromosome circulaire unique.
- Taille : généralement de l’ordre du micromètre, variant de [Formule] (mycoplasmes) à plus de [Formule] (certains spirochètes).
- Biomasse : représentent environ 15 % de la biomasse terrestre.
- Habitat : sol, eau, sources chaudes, fonds océaniques, déchets radioactifs, croûte terrestre.
- Rôle écologique : décomposition de la matière organique, fixation de l’azote, digestion chez les animaux.
1.2 - Importance pour l’homme
- Flore commensale : la majorité des bactéries sont inoffensives, certaines indispensables (synthèse de protéines, vitamines, éducation immunitaire).
- Pathogènes : responsables de maladies graves (ex. peste au XIV[Formule] siècle).
- Microbiote humain : neuf cellules sur dix dans notre corps sont des microbes.
2 - Morphologie des bactéries
L’étude morphologique est la première étape de l’identification bactérienne, essentielle en diagnostic médical. L’observation microscopique, souvent après coloration, oriente le diagnostic.
2.1 - Formes principales des bactéries
Quatre formes morphologiques majeures sont distinguées :
-
Coques (formes sphériques)
Exemples :
- Staphylococcus aureus (amas en grappes)
- Streptococcus pyogenes (chaînettes)
-
Bacilles (formes bâtonnets)
Exemples :
- Listeria monocytogenes (listériose)
- Mycobacterium tuberculosis (tuberculose)
-
Vibrions (formes incurvées)
Exemple :
- Vibrio cholerae (choléra)
-
Spirilles et spirochètes (formes spiralées)
Exemples :
- Treponema pallidum (syphilis)
- Helicobacter pylori (ulcère gastroduodénal)
2.2 - Groupements caractéristiques
Certains groupements cellulaires sont typiques et facilitent l’identification :
- Diplocoques (groupement par deux) : Streptococcus pneumoniae (pneumonie).
- Bacille en grain de café : Neisseria meningitidis (méningocoque).
- Amas ou grappes de raisin : Staphylococcus aureus.
- Chaînettes : Streptococcus pyogenes.
3 - Structure cellulaire des bactéries
Les bactéries possèdent des structures constantes, communes à toutes, et des structures facultatives, présentes selon l’espèce ou les conditions.

3.1 - La paroi bactérienne
3.1.1 - Rôle et caractéristiques
- Enveloppe rigide conférant forme et résistance à la pression osmotique interne.
- Participe aux propriétés antigéniques et à la virulence.
- Permet la distinction entre bactéries Gram positives et Gram négatives.
3.1.2 - Structure chimique
La paroi est principalement composée de peptidoglycane, un hétéropolymère formé par l’alternance de deux sucres aminés :
- N-acétylglucosamine (NAG)
- N-acétylmuramique (NAM)

3.1.3 - Différences entre paroi Gram + et Gram -
| Caractéristique | Paroi Gram + | Paroi Gram - |
|---|
| Épaisseur | Épaisse (jusqu'à 95 % peptidoglycane) | Fine (5 à 10 % peptidoglycane) |
| Membrane externe | Absente | Présente |
| Lipides | Peu nombreux, acides téichö̈ques | 10-20 % lipopolysaccharides (LPS) |
| Espace périplasmique | Réduit | Important |
Les acides téichö̈ques (Gram +) et les lipopolysaccharides (Gram -) jouent un rôle dans l’antigénicité et la pathogénicité.
3.2 - Coloration de Gram
Inventée en 1884 par Hans Christian Gram, cette technique différencie les bactéries selon leur paroi.
| Étape | Réactif | Effet sur les bactéries |
|---|
| 1 | Cristal violet | Toutes les cellules deviennent violettes |
| 2 | Iode/iodure | Fixe la coloration violette |
| 3 | Alcool (dénaturant) | Décolore les Gram négatives, Gram + restent violettes |
| 4 | Safranine (contre-colorant) | Recoloration en rose des Gram négatives; Gram + restent violettes |

3.3 - Membrane cytoplasmique
3.3.1 - Structure
- Double couche phospholipidique avec protéines intégrées (intrinsèques) et périphériques (extrinsèques).
- Aquaporines facilitent le passage de l’eau.

3.3.2 - Rôle
- Barrière sélective contrôlant le passage des nutriments et déchets.
- Contient enzymes de la chaîne respiratoire pour la production d’ATP.
- Site de formation du mésosome (rôle dans la division cellulaire, non formellement démontré).
3.4 - Espace périplasmique
- Situé entre la membrane cytoplasmique et la paroi (Gram +) ou membrane externe (Gram -).
- Contient enzymes de nutrition et protéines de transport.
3.5 - Cytoplasme
- Gel colloïdal à 70 % d’eau, contenant sels minéraux, chromosome bactérien, ribosomes, ARN et inclusions de réserves (organiques ou inorganiques).
- Certaines bactéries possèdent des inclusions spécifiques : vacuoles d’air (flottabilité), chromatophores (photosynthèse).
3.6 - Génome bactérien
- Chromosome unique, circulaire, double brin d’ADN dans le cytoplasme.
- Support de l’information génétique, transcrit en ARNm puis traduit en protéines.

3.7 - Plasmides
3.7.1 - Structure
- Molécules d’ADN circulaire de petite taille, entre [Formule] et [Formule] de la taille du chromosome.

3.7.2 - Propriétés
- Réplication autonome, non indispensable à la survie.
- Facilitent le transfert horizontal de gènes entre bactéries (conjugaison via pili sexuels).
- Portent des gènes conférant des avantages sélectifs :
- Résistance aux antibiotiques, antiseptiques, métaux toxiques (argent, bore, bismuth, cadmium), rayons UV.
- Production de substances pathogènes (entérotoxines).

3.8 - Pili
- Pili communs : nombreux, courts, surtout chez Gram -, facilitent adhésion et mobilité.
- Pili sexuels : peu nombreux, impliqués dans la conjugaison et transfert de plasmides.
Remarque : Pili sexuels ne participent pas à la reproduction bactérienne, qui est asexuée.
3.9 - Flagelles
- Structures protéiques responsables de la mobilité.
- Nombre variable (1 à 30).
- Localisation :
- Polaire (un ou plusieurs flagelles à un pôle)
- Péritriche (répartis sur toute la surface)



- Possèdent des propriétés antigéniques, induisant une réponse immunitaire.
3.10 - Capsule
3.10.1 - Définition
- Enveloppe protectrice rigide, visible comme un halo clair autour de certaines bactéries immobiles (ex. pneumocoques, méningocoques).

3.10.2 - Propriétés
- Augmente la virulence en empêchant la phagocytose (diminution adhésion macrophages, chimiotactine).
- Facilite l’adhésion aux surfaces (ex. paroi intestinale).
- Propriétés antigéniques (induction d’anticorps).
- Protection contre UV, agents physiques et chimiques.
3.11 - Spore (endospore)
3.11.1 - Définition et morphologie
- Forme de résistance élaborée par certaines bactéries (ex. Clostridium, Clostridioides) en conditions défavorables.
- Corpuscule sphérique ou ovoïde à l’intérieur de la bactérie.

3.11.2 - Sporulation (7-10 heures)
- Formation d’un filament axial avec condensation des génomes.
- Invagination de la membrane cytoplasmique formant un septum.
- Englobement de la petite cellule par la grande (pré-spore).
- Formation du cortex et des tuniques par accumulation de substances.
- Déshydratation de la spore.
- Lyse de la cellule-mère, libérant la spore mûre.

3.11.3 - Propriétés
- Dormance : absence d’activité métabolique, résistance à la dessiccation et au vieillissement (viabilité plusieurs années).
- Thermorésistance : résiste à 70-80[Formule]C pendant 10 minutes, nécessitant stérilisation à haute température.
- Résistance aux agents chimiques (antibiotiques, antiseptiques), UV, rayons gamma.
3.11.4 - Germination
- En conditions favorables (température, pH, eau), la spore se réhydrate et redevient une cellule végétative capable de multiplication.
4 - Exemples de bactéries pathogènes et leur classification
La classification des bactéries pathogènes repose notamment sur la coloration de Gram, la morphologie et les caractéristiques spécifiques.
4.1 - Bactéries Gram positives
4.1.1 - Streptocoques
- Streptococcus pyogenes (Streptocoque bêta-hémolytique du groupe A, SGA) : angines bactériennes, impétigo, scarlatine, érysipèle. Présent en chaînettes.
- Streptococcus pneumoniae (pneumocoque) : infections ORL et pulmonaires, diplocoques en forme de « 8 ».
4.1.2 - Listeria monocytogenes
- Bacille responsable de la listériose, infection alimentaire grave.
- Se multiplie à basse température (~4[Formule]C).
- Risque accru chez immunodéprimés et femmes enceintes (transmission intraplacentaire).

4.1.3 - Mycobacterium tuberculosis
- Bacille de Koch, responsable de la tuberculose.
- Transmission aérienne par gouttelettes respiratoires.
- Troisième cause de mortalité infectieuse mondiale.
4.1.4 - Corynebacterium diphtheriae
- Bacille Gram positif produisant une exotoxine.
- Cause la diphtérie, maladie respiratoire grave.
- Transmission par gouttelettes respiratoires.
- Vaccination efficace, épidémies rares.
4.1.5 - Clostridium et Clostridioides
- Bacilles sporulés Gram positif produisant des toxines.
- Exemples :
- Clostridium tetani (tétanos)
- Clostridium botulinum (botulisme)
- Clostridioides difficile (diarrhées pseudomembraneuses)
4.2 - Bactéries Gram négatives
4.2.1 - Neisseria
- Diplocoques en forme de grain de café.
- Neisseria meningitidis (méningocoque) : infections invasives, plusieurs sérogroupes (C 25 %, B 15 %), létalité ~10 %.
- Neisseria gonorrhoeae (gonocoque) : infection sexuellement transmissible, complications féminines (salpingites, stérilité).
4.2.2 - Helicobacter pylori
- Bactérie spiralée et flagellée, colonise l’estomac.
- Infection chronique fréquente (~50 % population mondiale).
- Cause ulcères gastriques et facteur de risque du cancer gastrique.
4.2.3 - Salmonelles (Salmonella)
- Bacilles Gram négatif entérobactéries.
- Salmonella enterica : toxi-infections alimentaires collectives (TIAC).
- Sérotype Typhi : fièvre typhoïde, maladie grave, rare en pays développés.
4.2.4 - Escherichia coli
- Bacille Gram négatif, colibacille.
- Flore commensale intestinale, majoritairement inoffensive.
- Certaines souches pathogènes causent intoxications alimentaires, syndrome hémolytique et urémique (SHU), cystites.
4.2.5 - Chlamydia trachomatis
- Bactérie intracellulaire, tropisme pour épithéliums génitaux, rectaux et oculaires.
- Très répandue (10-20 % population mondiale).
- Cause urétrites et salpingites non gonococciques, souvent asymptomatique (60 %).
- Complications : infertilité, grossesse extra-utérine.
4.3 - Synthèse des bactéries pathogènes
[Diagramme]
Conclusion : Points clés à retenir
- Les bactéries sont des procaryotes unicellulaires, omniprésentes et écologiquement essentielles.
- Leur morphologie (formes, groupements) est un outil diagnostique fondamental.
- La paroi bactérienne, notamment la distinction Gram + / Gram -, est centrale pour leur classification et leur pathogénicité.
- Les structures cellulaires comme la membrane cytoplasmique, l’espace périplasmique, le cytoplasme, le génome, les plasmides, pili, flagelles, capsule et spores confèrent des fonctions spécifiques et adaptations.
- La connaissance des bactéries pathogènes majeures permet de comprendre les mécanismes infectieux et d’orienter les traitements.
Cette fiche synthétise les connaissances essentielles sur la cellule bactérienne et sa morphologie, base indispensable pour l’étude microbiologique et médicale.